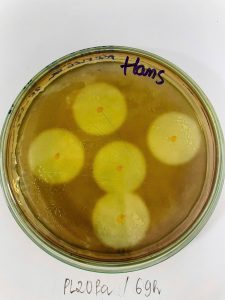
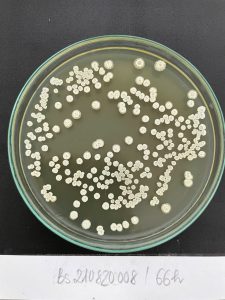
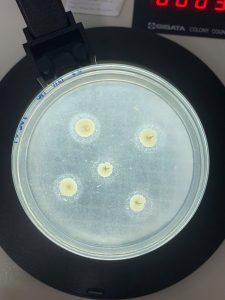
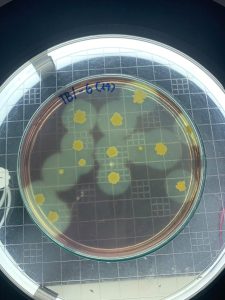
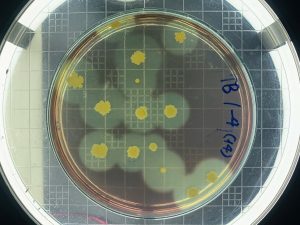
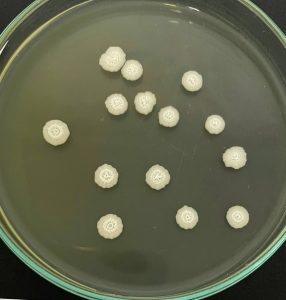
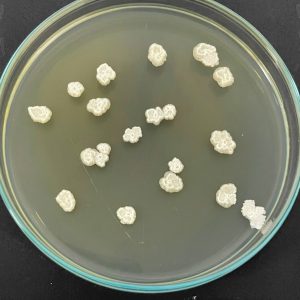
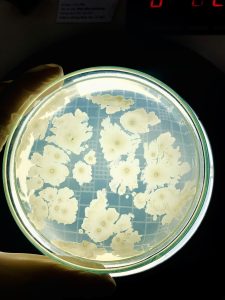

Trung tâm Khảo kiểm nghiệm phân bón Quốc gia nghiên cứu và ứng dụng chuyển giao tới các Doanh nghiệp Một số dòng Bacillus sp. an toàn với con người và môi trường, hoạt tính cao được tuyển chọn và lưu trữ tại Trung tâm Khảo kiểm nghiệm Phân bón Quốc gia
Trung tâm Khảo kiểm nghiệm phân bón Quốc gia nghiên cứu và ứng dụng chuyển giao tới các Doanh nghiệp Một số dòng Bacillus sp. an toàn với con người và môi trường, hoạt tính cao được tuyển chọn và lưu trữ tại Trung tâm Khảo kiểm nghiệm Phân bón Quốc gia. Ứng dụng phân giải phụ phẩm nông nghiệp thành phân bón, khử mùi hôi chuồng trại, phân giải xenlulo, hợp chất photpho khó tan giúp cải tạo đất, ngoài ra còn có khả năng kích thích sinh trưởng cây trồng, hỗ trợ phòng trừ sâu, nấm và vi khuẩn gây bệnh trên cây trồng (đốm lá, mốc tro, phấn trắng, đốm vòng, v.v), phù hợp phun trực tiếp trên đồng ruộng, phối trộn sản xuất phân bón.

- Trồng thành công sâm Hàn Quốc theo hướng hữu cơ tại Vĩnh Phúc
- Trung tâm Khảo kiểm nghiệm Phân bón Quốc gia hợp tác liên kết Bình Xuyên – Hightech chuyển giao các giải pháp kỹ thuật, công nghệ ứng dụng vi sinh trong sản xuất phân bón hữu cơ, chăn nuôi, thuỷ sản, môi trường, cảu tạo đất, trồng Nhân sâm, Wasabi tại Vĩnh phúc
- Công ty TNHH Nông Lâm Nghiệp Ứng Dụng Công nghệ cao Bình Xuyên áp dụng công nghệ AI vào việc trồng nhân sâm Hàn Quốc
- Đoàn công tác của Hàn Quốc thăm mô hình nông nghiệp Công nghệ cao do Trung tâm Khảo kiểm nghiệm phân bón Quốc gia chuyển giao công nghệ trồng nhân sâm Hàn Quốc cho công ty TNHH Nông Lâm Nghiệp ứng dụng Công Nghệ Cao Bình Xuyên tại huyện Bình Xuyên tỉnh Vĩnh Phúc
- Trung tâm Khảo kiểm nghiệm Phân bón Quốc gia hợp tác liên kết với Công ty ECOBIZINET Hàn Quốc, Công ty TNHHUDNLN CNC Bình Xuyên – Bĩnh phúc nghiên cứu, sản xuất, ứng dụng và chuyển giao các sản phẩm Vi sinh trên lĩnh vực Phân bón, cải tạo đất, Thuỷ sản, chăn nuôi, Môi trường, Rác thải…theo chuỗi giá trị tuần hoàn hữu cơ… Ts Trần Văn Thanh 0909111840. Phụ trách phòng kiểm nghiệm 0979682055
- Quyết định 3745/QĐ-TTTV-KHCN ngày 27/10/2025 của Cục Trồng trọt và Bảo vệ thực vật, về việc ủy quyền thực hiện kiểm tra nhà nước chất lượng phân bón nhập khẩu
- Nghị định 130/2022/NĐ-CP ngày 31/12/2022, sửa đổi, bổ sung một số điều của Nghị định số 84/2019/NĐ-CP ngày 14 tháng 11 năm 2019
- Nghị định 84/2019/NĐ-CP ngày 14/11/2019 quy định về quản lý phân bón
- Nghị định 31/2023/NĐ-CP ngày 9/6/2023, quy định xử phạt vi phạm hành chính về Trồng trọt
- Luật Trồng trọt số 31/2018/QH14 ngày 22/12/2018


